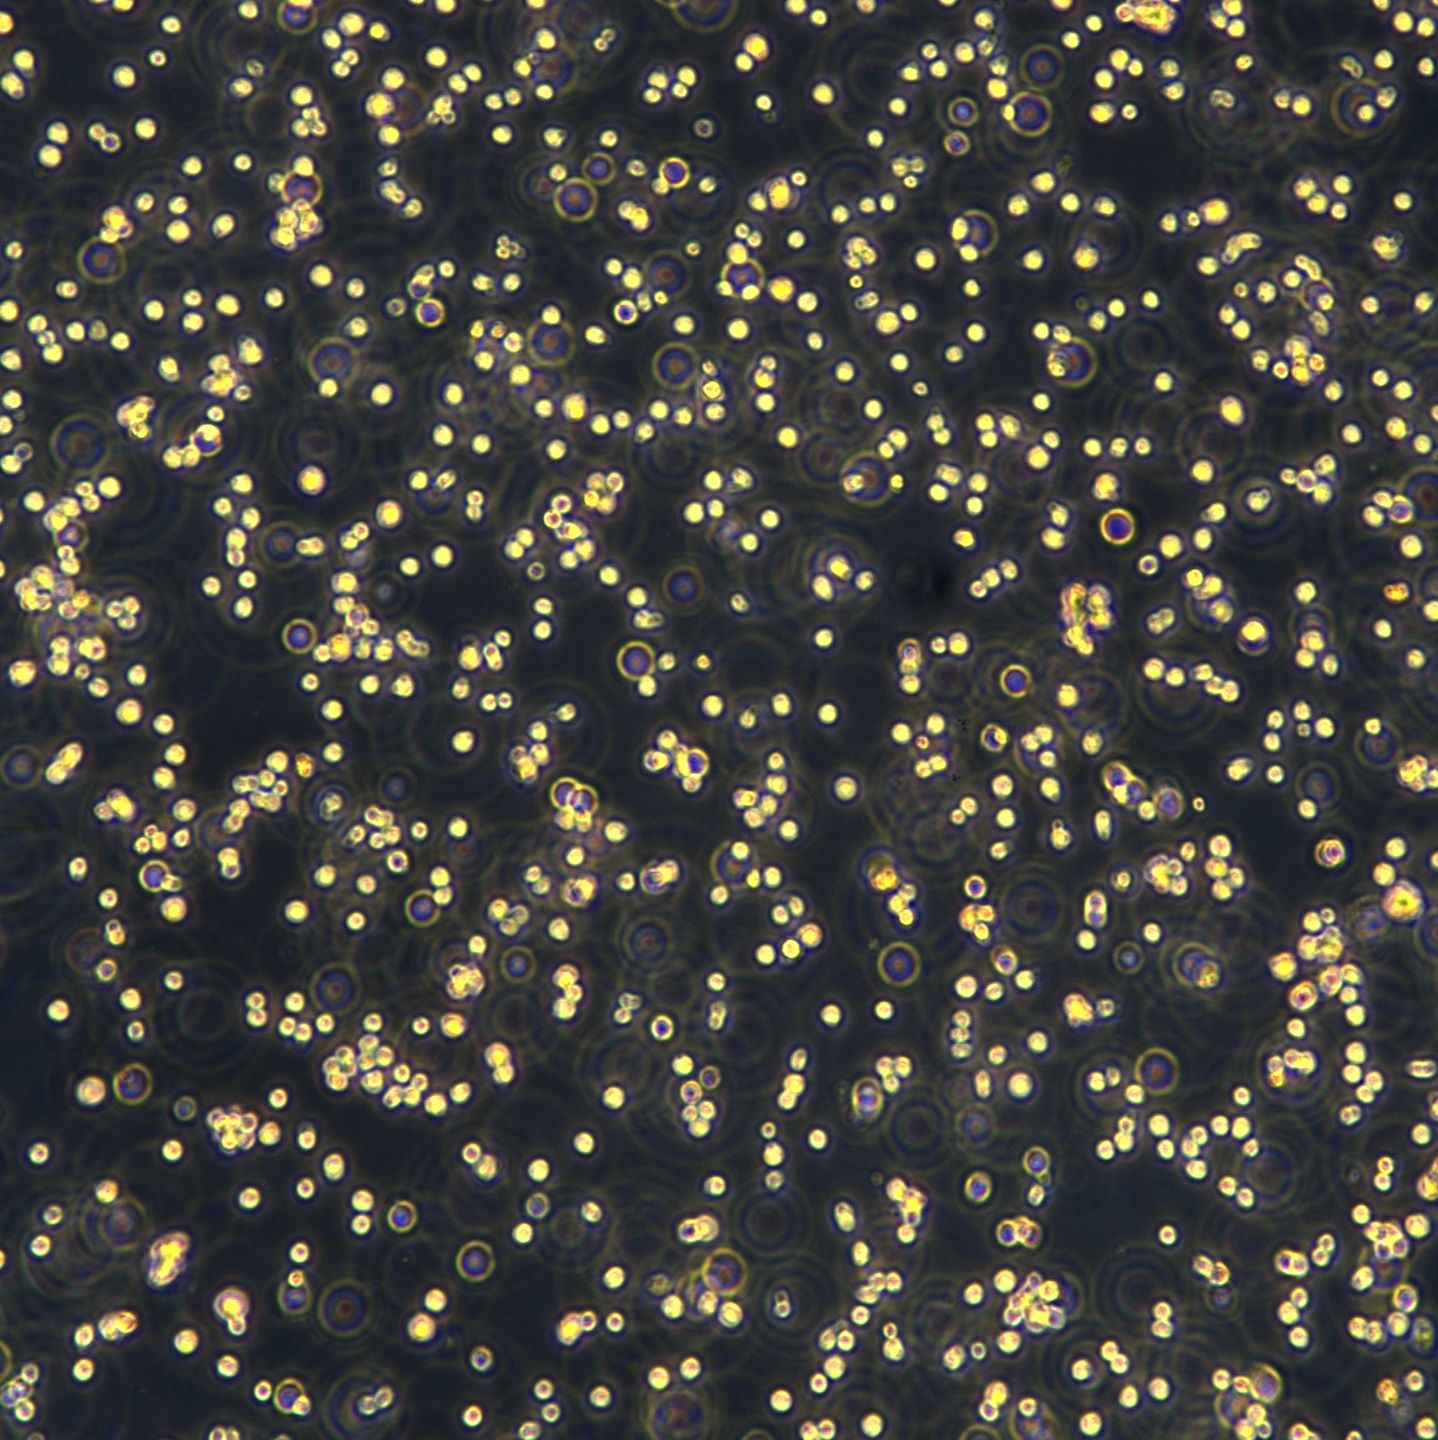
产品封面图

相关产品推荐更多 >
万千商家帮你免费找货
0 人在求购买到急需产品
- 详细信息
- 文献和实验
- 技术资料
- 英文名:
U2932
- 库存:
99
- 组织来源:
腹水(Ascites)
- 相关疾病:
大B细胞淋巴瘤(Large B-cell lymphoma)
- 物种来源:
人源(Homo sapiens)
- 细胞形态:
B细胞淋巴瘤(B cell lymphoma)
- 年限:
29岁(29 years)
- 生长状态:
悬浮生长(Suspension)
- 规格:
T25
| 规格 | T25 |
| 货号 | CTCC-007-0253 |
| 种属 | 人源(Homo sapiens) |
| 组织来源 | 腹水(Ascites) |
| 疾病 | 大B细胞淋巴瘤(Large B-cell lymphoma) |
| 年龄 | 29岁(29 years) |
| 培养体系 | 该细胞系培养所用基本培养基为 RPMI1640 Medium,配置完全培养基时 需加入10%FBS,1% Anti-Anti。 |
| 细胞形态 | B细胞淋巴瘤(B cell lymphoma) |
| 生长特性 | 悬浮生长(Suspension) |




风险提示:丁香通仅作为第三方平台,为商家信息发布提供平台空间。用户咨询产品时请注意保护个人信息及财产安全,合理判断,谨慎选购商品,商家和用户对交易行为负责。对于医疗器械类产品,请先查证核实企业经营资质和医疗器械产品注册证情况。
文献和实验dj070886 从CST新买了一支U0126,是冻干粉,而且是用CST公司那种装抗体的管子装的,没有封口,请问这种状态下的粉子是有菌的还是无菌的?求助啊,求助 chp_cn 应该是无菌的,你应该到culture hood中稀释好,分装到无菌的小管中保存。 good luck! seagate 就算有菌,拿dmso溶解为母液就可以用了,dmso号称万能
佚名 u检验(亦称T检验),它根据正态分布规律作假设检验(显著性检验)。当样本含量增大时,样本均数的分布趋向正态,这可看图6.1,t分布曲线以ν=9的一条比ν=3的更近似正态分布,再看附表3,表最下一行ν为∞时的t分布即是正态分布。故u检验用于大样本。 在仅有一条的标准正态曲线上,以u=1.96与-1.96为界,从此处向外的尾部面积共占
第一号 园子里的各位战友及版主: 本人在做抑制MAPK通道,对甲状腺癌细胞分化的影响。使用的抑制剂是U0126,按照文献报道,浓度是10um。但在加药后24h,可见细胞大量的漂浮(已排除污染),而国外文献报道,U0126要持续作用5天,且每天更换新液。 请问,U0126对细胞有无毒性?为何我的细胞在作用24h后就见大量死亡? 各位战友及版主能帮我分析分析吗? 苍茫云海间 当然有毒,
技术资料